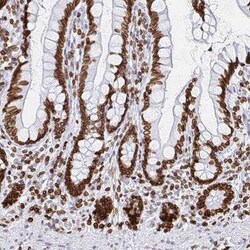
Lamin B1 Antibody, Novus Biologicals 25 &mu;L, Unconjugated:Anticorps,

missing translation for 'onlineSavingsMsg'
Learn More
Learn More
Lamin B1 Antibody, Novus Biologicals™
Rabbit Polyclonal Antibody
Marque: Novus Biologicals NBP2-48966-25ul
Les retours ne sont pas autorisés pour ce produit.
Afficher la politique du retour.
Description
Lamin B1 Polyclonal antibody specifically detects Lamin B1 in Human samples. It is validated for Western Blot, Immunohistochemistry, Immunocytochemistry/ Immunofluorescence, Immunohistochemistry (Paraffin)
Spécification
| Lamin B1 | |
| Polyclonal | |
| Western Blot 0.04 - 0.4 μg/mL, Immunohistochemistry 1:50 - 1:200, Immunocytochemistry/ Immunofluorescence 0.25-2 μg/mL, Immunohistochemistry-Paraffin 1:50 - 1:200 | |
| ADLD, lamin B1, lamin-B1, LMN, LMN2, LMNB, MGC111419 | |
| This antibody was developed against a recombinant protein corresponding to amino acids: RTTRGKRKRVDVEESEASSSVSISHSASATGNVCIEEIDVDGKFIRLKNTSEQDQPMGGWEMIRKIGDTSVSYKYTSRYVLK | |
| 25 μL | |
| Apoptosis, Cancer, Core ESC Like Genes, Loading Controls, Stem Cell Markers, Tumor Suppressors | |
| 4001 | |
| Store at 4°C short term. Aliquot and store at -20°C long term. Avoid freeze-thaw cycles. | |
| IgG |
| Western Blot, Immunohistochemistry, Immunofluorescence, Immunohistochemistry (Paraffin) | |
| Unconjugated | |
| PBS (pH 7.2), 40% Glycerol | |
| Rabbit | |
| Immunogen affinity purified | |
| RUO | |
| Primary | |
| Human | |
| Purified |
Correction du contenu d'un produit
Veuillez fournir vos retours sur le contenu du produit en remplissant le formulaire ci-dessous.
Nom du produit
Vous avez repéré une opportunité d'amélioration ?Partager une correction de contenu